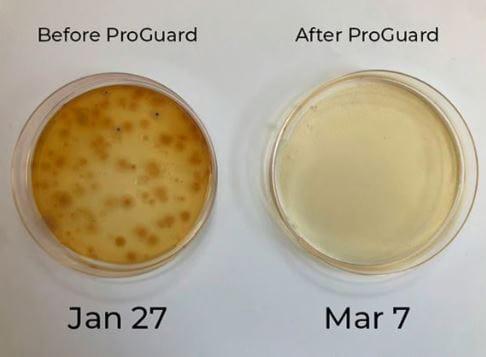
The Hydro Bros

Beschreibung
Defender DXB 100 with BPI has been designed and engineered to deliver sanitization that is proven to reduce & eradicate surface and airborne pathogens for high-load environments in greenhouses using the ProGuard Sanitization Technology.
Manual / Installation instructions here.
This unit covers 500 square feet (46 square meters) based on a room height of 3.6m
Why do grow rooms need an air sanitiser?
An air sanitiser can prevent mildew and moulds that are harmful to your plants. If you’ve ever dealt with powdery mildew, you know why growers need air sanitation. Since grow rooms tend to have high humidity, they're highly susceptible to powdery mildew and other moulds, plus pathogens that can destroy crops quickly.
In short, powdery mildew can fuck your shit up. Here are a few reasons how they do that:
- Powdery mildew spores can be carried by the wind, air exhaust and ventilation systems, pets, and even growers and employees. Practically any living organism can transport the fast-spreading mildew.
- Mildew spores can stay dormant until environmental conditions are just right for them to thrive. Powdery mildew has a 4-7 day post-inoculation window. During that time it’s practically invisible, so it’s hard to know when powdery mildew or other moulds are waiting to appear, reproduce and spread.
- Powdery mildew is able to depress the photosynthesis process of plants significantly. That means your plants won’t take up nutrients and energy as efficiently for healthy growth.
- Powdery mildew can affect seedlings, clones, veg plants, and flowering plants.
- Most fungicidal sprays that may be able to treat powdery mildew, other moulds, and mildews have a detrimental effect on bud quality and safety. Regulations bar the use of many that otherwise would be effective.
- Crops affected by powdery mildew are harmful to consume. The plants are likely to fail regulatory testing for mould content.
Air sanitizers in grow rooms are an advance that’s been added to best commercial practices. Sanitisers effectively “clean” the air of harmful pathogens and spores for optimal environments.
The most effective indoor air sanitizers, including ProGuard, use UV energy and other technology, transforming moisture molecules in the air into an ionized vapour that can kill pathogens. By contrast, some other air sanitation models emit potentially hazardous gases or chemicals into the air as they claim to be purifying it.
The ProGuard Difference
Innovative Solutions’ ProGuard systems use a process called Active Sanitization Distribution. It distributes the sanitizing effect into the environment, killing pathogens at their point of origin, both in the air and on surfaces #SeekAndDestroy
The ProGuard™ air sanitiser was designed specifically for commercial grow rooms that are naturally high-density and high-humidity. Through a photocatalytic oxidation process, UV energy and a proprietary catalyst turn air moisture molecules into an ionized, mild form of hydrogen peroxide vapour that actively kills pathogens up to 99.9%, reducing mould and mildew threats. The result is an optimally clean environment that promotes plant health and helps crops pass microbial regulatory testing.
The ProGuard DXM Mini has been designed for grow rooms and dry rooms up to 250 square feet (circa 25 square metres) the DMX Mini can also benefit other smaller spaces, such as hallways. The power draw is a meagre 14 watts.
When greenhouse facilities look at the cost of losing an entire crop versus the cost of a system that can prevent the loss, the decision is easy.
DXB Mini with BPI is easy to install and maintain as it operates 24/7. ProGuard Sanitization has been tested and validated by reputable labs across the world to ensure safety and effectiveness in reducing mould, mildew, bacteria, viruses, voc’s and other dangerous pathogens.
Product Specifications
- Weight of Unit: 6.5 lbs.
- Cord Length: 4.5ft
- Dimensions (H x L x D):12” x 12.4” x 3.1”
- Electrical Input:100-240V – 50/60Hz
- Electrical Output: 12VDC 3A
- Power Consumption: Running 14 Watts – 22 Watts / 3 Amps
- Warranty: 2 Years